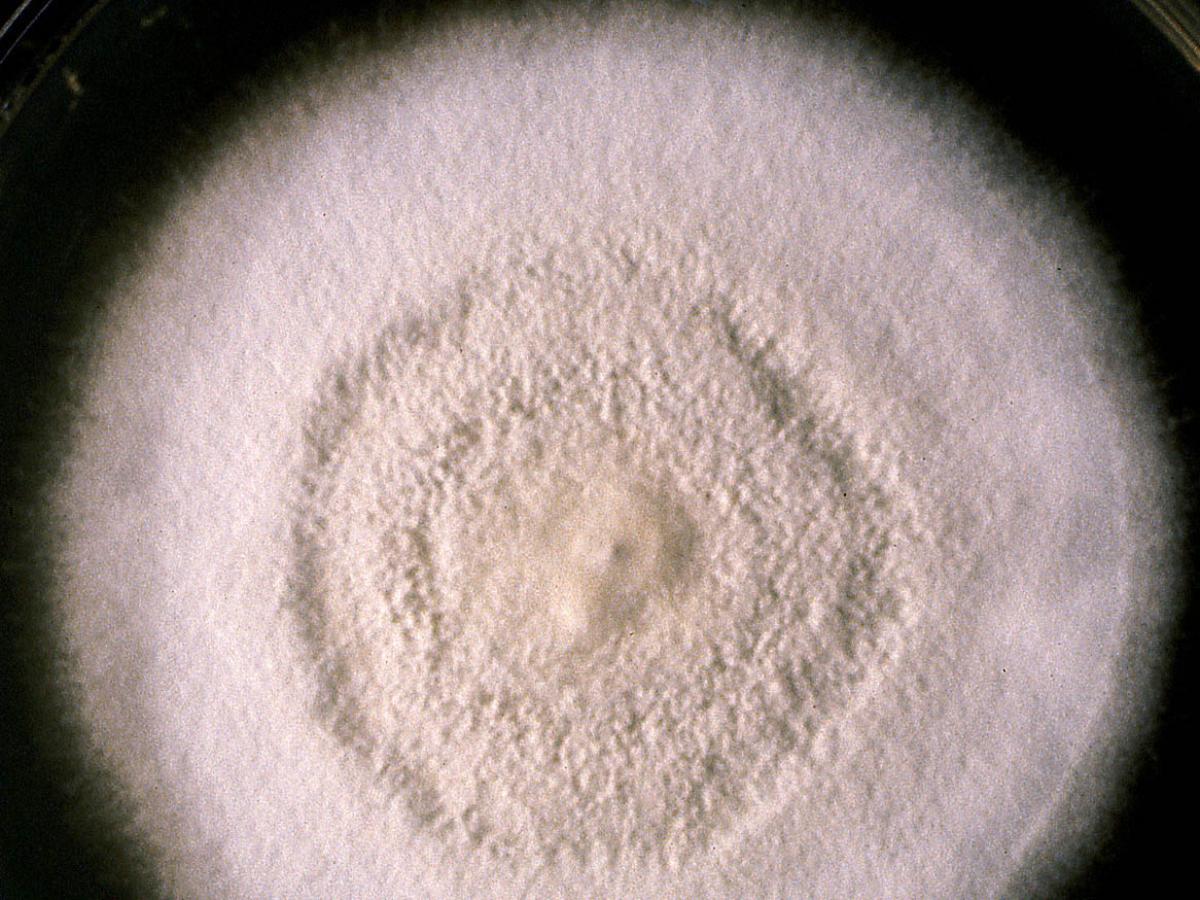
Culture

Status message
Correct! Excellent, you have really done well. Please find additional information below.
Unknown 53 = Chrysosporium tropicum
Culture: Colonies are moderately fast growing, flat, white to tan to beige in colour, often with a powdery or granular surface texture. Reverse pigment absent or pale brownish-yellow with age. RG-2 organism.
Microscopy: Hyaline, one-celled (ameroconidia) are produced directly on vegetative hyphae by non-specialized conidiogenous cells. Conidia are typically pyriform to clavate with truncate bases (6 to 7 by 3.5 to 4 um) and are formed either intercalary (arthroconidia), laterally (often on pedicels) or terminally. No macroconidia or hyphal spirals are seen.

Key features: Pyriform to clavate shaped conidia with truncated bases which may be formed either intercalary, laterally or terminally.
Comment: Species of Chrysosporium are occasionally isolated from skin and nail scrapings, especially from feet, but because they are common soil saprophytes they are usually considered as contaminants. There are about 70 species of Chrysosporium, several are keratinophilic with some also being thermotolerant, and cultures may closely resemble some dermatophytes, especially Trichophyton mentagrophytes, and some strains may also resemble cultures of Histoplasma and Blastomyces.
About Chrysosporium Back to virtual assessment